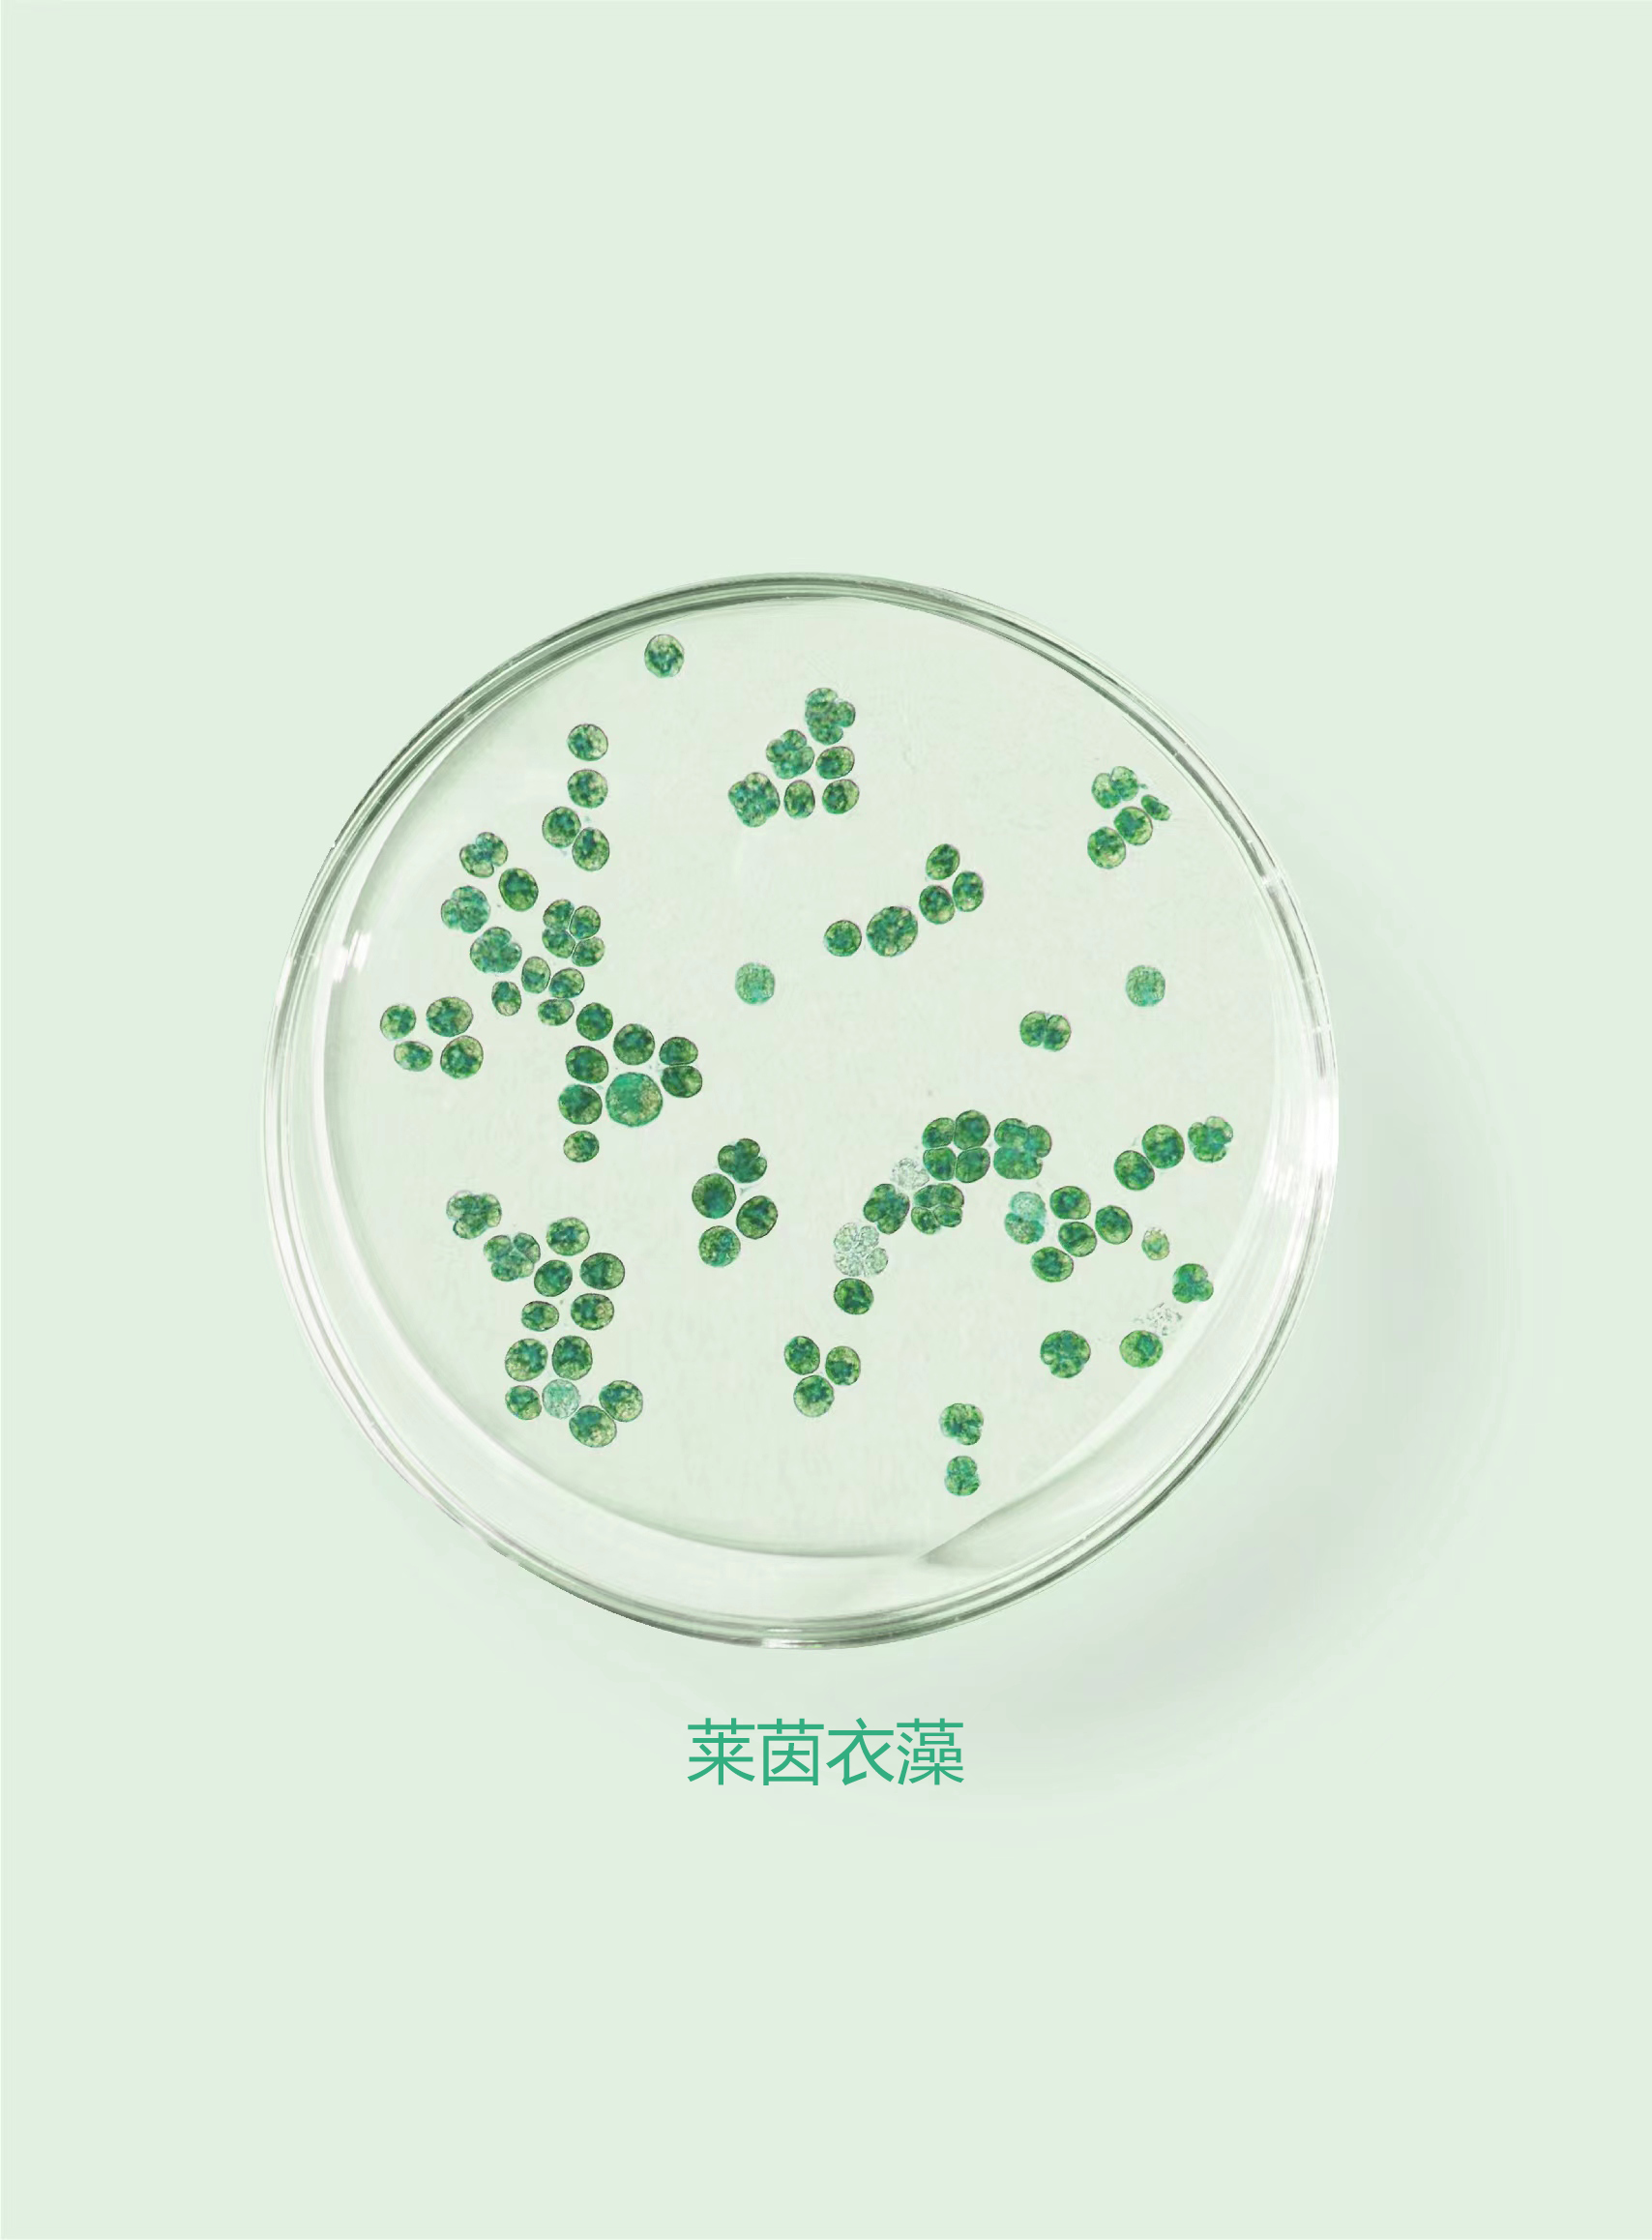
reinhardtii ,又称"莱氏衣藻","莱哈衣藻",简称"衣藻")是山西透云生物

衣藻是什么生物

莱茵衣藻的前世今生
图片尺寸720x757
衣藻的介绍
图片尺寸500x667
衣藻亦称"单衣藻",属于真核生物,绿藻纲,衣藻科.
图片尺寸1080x816
衣藻属于单细胞的真核生物,也叫作"单衣藻",通常都分布在水沟和积水
图片尺寸640x406
曾经独霸地球的单细胞生物 - 抖音
图片尺寸1080x1439
衣藻属于什么生物
图片尺寸525x351
衣藻是藻类植物吗?
图片尺寸640x427
衣藻的分布范围
图片尺寸600x400
衣藻属
图片尺寸1600x1200
衣藻是一种单细胞生物,属于藻类植物.
图片尺寸640x466
5《显微镜下的各种生物》(浙教版七年级上)ppt 衣藻 (1) 鞭毛 (2)
图片尺寸1080x810
初中生物3d视频衣藻
图片尺寸448x252
极地雪衣藻chlamydomonas nivalis,一种能在雪地上生存的绿藻
图片尺寸1024x576
衣藻的结构!
图片尺寸534x467
衣藻是什么生物
图片尺寸640x341
reinhardtii ,又称"莱氏衣藻","莱哈衣藻",简称"衣藻")是山西透云生物
图片尺寸1708x2316
衣藻
图片尺寸544x444
长治市潞城区:全球首条莱茵衣藻生产线进入试产阶段
图片尺寸640x806
单细胞的生物体ppt
图片尺寸1080x810
衣藻是生活在水中的单细胞藻类,能独立完成生命活动.
图片尺寸197x185